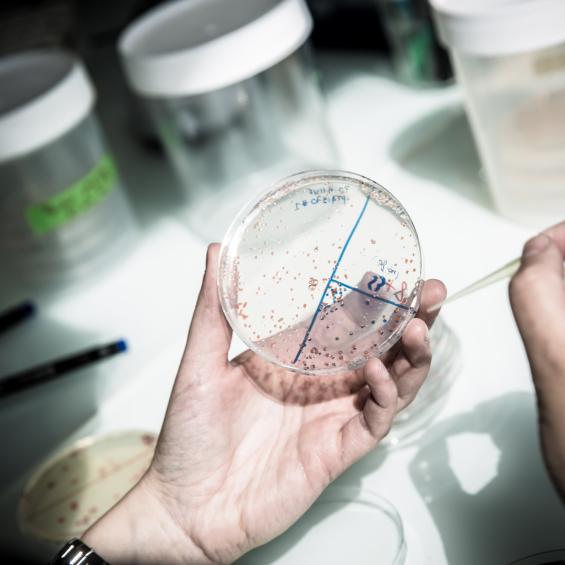

News & events

Biomedical Engineering Master Open Day

Fourteen IP Paris startups in the Next 40 2024
Enzyme mechanics, a lever for action against antimicrobial resistance

Antimicrobial resistance: prevention for a better cure

When bacteria become resistant

Consortium led by IP Paris and HEC Paris wins a €70million call for AI Cluster projects

Two EuroTech conferences dedicated to African research and water protection

A look back at INNOV'NIGHT IP Paris 2024

IP Paris ranked 6th in the 2024 Times Higher Education (THE) Young University Rankings

Physics takes the plunge

Bruno Cattan appointed Director of Innovation and Entrepreneurship at IP Paris
